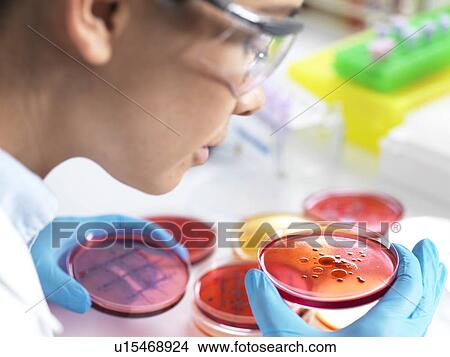

Fotosearch Royalty Free Stock Photography
Digital images licensed by Publitek, Inc.
Fotosearch and Photosearch are trademarks of Fotosearch, LLC
All rights reserved © 2025-12-10
Microbiological research Picture
Microbiological research
u15468924 | Lushpix | Royalty Free
Add to Lightbox
Share Image
Keywords
analysis, bacteria, biological research, biology, biomedical, culture, examining, experiment, female, lab, laboratory, latex gloves, looking down, medical research, microbe, microbiology, microorganism, one person, petri dish, pharmaceutical research, protective gloves, research, scientist, working, stock image, images, royalty free photo, stock photos, stock photograph, stock photographs, picture, pictures, graphic, graphics, fine art prints, print, poster, posters, mural, wall murals, u15468924
analysis, bacteria, biological research, biology, biomedical, culture, examining, experiment, female, lab, laboratory, latex gloves, looking down, medical research, microbe, microbiology, microorganism, one person, petri dish, pharmaceutical research, protective gloves, research, scientist, working, stock image, images, royalty free photo, stock photos, stock photograph, stock photographs, picture, pictures, graphic, graphics, fine art prints, print, poster, posters, mural, wall murals, u15468924
Show Keywords
- Mobile/Small Web Resolution (150 KB)3.7" x 2.8" @ 72dpi JPG13
- Web Resolution (500 KB)6.7" x 5" @ 72dpi JPG32
- Low Resolution (1 MB)9.5" x 7.1" @ 72dpi JPG68
- Medium Resolution (10 MB)7.2" x 5.4" @ 300dpi JPG140
- High Resolution (28 MB)12" x 9" @ 300dpi JPG215
- Ultra High Resolution (64.9 MB)18.3" x 13.8" @ 300dpi JPG250
View larger image sizes
View Lushpix license agreement

























